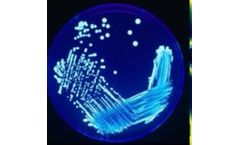
Towertech - Model 1000 - Proportional Timer Controller

- Home
- Equipment
Refine by
Towertech Environmental Equipment & Supplies
6 equipment items found
Manufactured by:Beacon Water Treatments Limited based inIrchester, UNITED KINGDOM
Provides TDS conductivity bleed control, Dual Biocide with 15-1 ratio facility, proportional inhibitor Dosing, 0-6 bleed lockout timer activated by either biocide pump. Both manual override switches & time adjustments to all outputs on the facia plate of ...
Manufactured by:Beacon Water Treatments Limited based inIrchester, UNITED KINGDOM
The controller provides two timed outputs for bleed & dose control on cooling towers, both output times are adjustable and override switches with integral led are mounted on the front of the controller, indication of pulse signal from the water meter is confirmed through the red LED ...
Manufactured by:Beacon Water Treatments Limited based inIrchester, UNITED KINGDOM
Due to the advance in recent years of both electronic and chemical technology, it has become apparent that today's Water Treatment professional requires a single controller developed to suit most water treatment applications, where TDS conductivity control is not required. The Towertech 3000 has been developed for this purpose to finally give a choice to the Chemical industry, with Dual Biocide, ...
Manufactured by:Beacon Water Treatments Limited based inIrchester, UNITED KINGDOM
The controller provides TDS Bleed & inhibitor dosing with Bromine & Biocide dosing. Two lockouts are provided for bleed (0-1 hour) and one hour fixed lockout to the bromine activated by the biocide ...
Manufactured by:Beacon Water Treatments Limited based inIrchester, UNITED KINGDOM
The controller has a single timed output suitable for bleed control or dosing of chemicals on many water treatment applications, the output time is adjustable and a override switch with integral red led is mounted on the front of the ...
Manufactured by:Beacon Water Treatments Limited based inIrchester, UNITED KINGDOM
The Towertech 2000 Controller is a simple to install and operate unit. With a single set point the unit can be used for the following ...